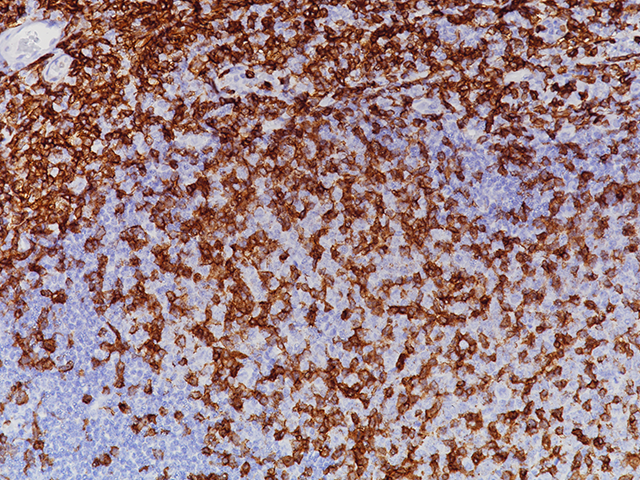
CD4 RM Biocare Medical

If you are having a hard time accessing the Biocare Medical Decloaking Chamber page, Our website will help you. Find the right page for you to go to Biocare Medical Decloaking Chamber down below. Our website provides the right place for Biocare Medical Decloaking Chamber.

https://www.google.fr › maps › about
L Assistant Google est d sormais int gr Google Maps Vous pouvez ainsi envoyer des messages effectuer des appels couter de la musique et obtenir de l aide en mode mains libres tout en

https://maps.google.fr › intl › ALL_fr › maps › about
Discover the world with Google Maps Experience Street View 3D Mapping turn by turn directions indoor maps and more across your devices

https://www.google.com › intl › fr › maps › about › mymaps
Partez la d couverte du monde avec Google Maps Essayez Street View la cartographie 3D la navigation d taill e les plans d int rieur et bien plus sur tous vos appareils

https://support.google.com › maps › answer
Google Maps vous permet d obtenir des itin raires en voiture en transports en commun pied en partage de course v lo en avion ou moto Si plusieurs itin raires vers votre destination sont

https://maps.google.fr
Find locations directions and explore the world with Google Maps on your devices

https://www.clubic.com
Vous allez skier pendant les vacances Bonne nouvelle Google Maps a pens vous une option tr s pratique revient dans l application

https://maps.google.com › intl › en_in › maps › about
Discover the world with Google Maps Experience Street View 3D Mapping turn by turn directions indoor maps and more across your devices

https://play.google.com › store › apps › details
D couvrez et parcourez le monde avec s r nit gr ce Google Maps Trouvez les meilleurs itin raires en voiture pied v lo et en transports en commun tout en profitant de donn es sur le trafic en
https://www.presse-citron.net › google-maps-la-depuis-des...
Il tait temps Alors que Google Maps propose l affichage des feux de circulation depuis des ann es Waze y travaille enfin
Thank you for visiting this page to find the login page of Biocare Medical Decloaking Chamber here. Hope you find what you are looking for!